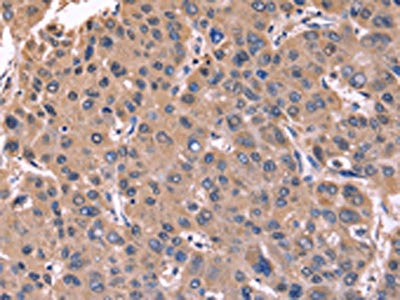

CSNK1D Antibody
-
中文名稱:CSNK1D兔多克隆抗體
-
貨號:CSB-PA193371
-
規格:¥1100
-
圖片:
-
The image on the left is immunohistochemistry of paraffin-embedded Human brain tissue using CSB-PA193371(CSNK1D Antibody) at dilution 1/50, on the right is treated with fusion protein. (Original magnification: ×200)
-
The image on the left is immunohistochemistry of paraffin-embedded Human liver cancer tissue using CSB-PA193371(CSNK1D Antibody) at dilution 1/50, on the right is treated with fusion protein. (Original magnification: ×200)
-
-
其他:
產品詳情
-
Uniprot No.:
-
基因名:
-
別名:Casein Kinase 1 delta antibody; Casein kinase I delta isoform antibody; Casein kinase I isoform delta antibody; CKI delta antibody; CKI-delta antibody; CKId antibody; CKIdelta antibody; CSNK 1D antibody; CSNK1D antibody; HCKID antibody; KC1D_HUMAN antibody; Protein kinase CK1 delta antibody
-
宿主:Rabbit
-
反應種屬:Human,Mouse,Rat
-
免疫原:Fusion protein of Human CSNK1D
-
免疫原種屬:Homo sapiens (Human)
-
標記方式:Non-conjugated
-
抗體亞型:IgG
-
純化方式:Antigen affinity purification
-
濃度:It differs from different batches. Please contact us to confirm it.
-
保存緩沖液:-20°C, pH7.4 PBS, 0.05% NaN3, 40% Glycerol
-
產品提供形式:Liquid
-
應用范圍:ELISA,IHC
-
推薦稀釋比:
Application Recommended Dilution ELISA 1:2000-1:5000 IHC 1:50-1:200 -
Protocols:
-
儲存條件:Upon receipt, store at -20°C or -80°C. Avoid repeated freeze.
-
貨期:Basically, we can dispatch the products out in 1-3 working days after receiving your orders. Delivery time maybe differs from different purchasing way or location, please kindly consult your local distributors for specific delivery time.
-
用途:For Research Use Only. Not for use in diagnostic or therapeutic procedures.
相關產品
靶點詳情
-
功能:Essential serine/threonine-protein kinase that regulates diverse cellular growth and survival processes including Wnt signaling, DNA repair and circadian rhythms. It can phosphorylate a large number of proteins. Casein kinases are operationally defined by their preferential utilization of acidic proteins such as caseins as substrates. Phosphorylates connexin-43/GJA1, MAP1A, SNAPIN, MAPT/TAU, TOP2A, DCK, HIF1A, EIF6, p53/TP53, DVL2, DVL3, ESR1, AIB1/NCOA3, DNMT1, PKD2, YAP1, PER1 and PER2. Central component of the circadian clock. In balance with PP1, determines the circadian period length through the regulation of the speed and rhythmicity of PER1 and PER2 phosphorylation. Controls PER1 and PER2 nuclear transport and degradation. YAP1 phosphorylation promotes its SCF(beta-TRCP) E3 ubiquitin ligase-mediated ubiquitination and subsequent degradation. DNMT1 phosphorylation reduces its DNA-binding activity. Phosphorylation of ESR1 and AIB1/NCOA3 stimulates their activity and coactivation. Phosphorylation of DVL2 and DVL3 regulates WNT3A signaling pathway that controls neurite outgrowth. EIF6 phosphorylation promotes its nuclear export. Triggers down-regulation of dopamine receptors in the forebrain. Activates DCK in vitro by phosphorylation. TOP2A phosphorylation favors DNA cleavable complex formation. May regulate the formation of the mitotic spindle apparatus in extravillous trophoblast. Modulates connexin-43/GJA1 gap junction assembly by phosphorylation. Probably involved in lymphocyte physiology. Regulates fast synaptic transmission mediated by glutamate.
-
基因功能參考文獻:
- Our results reveal a new mechanism of ZNF322A oncoprotein destruction regulated by the CK1delta/GSK3beta/FBXW7a axis. Deregulation of this signaling axis results in ZNF322A overexpression and promotes cancer progression PMID: 28581525
- Report temperature-compensated CKIdelta-dependent multi-site phosphorylation in mammals underlies temperature compensated phosphorylation in circadian clocks. PMID: 28886336
- Study describes a specific mechanism for the regulation of CK1delta activity by proline-directed kinases, and demonstrate the relevance of this regulation in the control of a key CK1delta substrate, the PER2 protein. PMID: 28545154
- Protein kinase C alpha (PKCalpha) is able to phosphorylate CK1delta at its C-terminally located residues S328, T329, and S370. PMID: 26803658
- the results suggest that CK1delta activity can be modulated by the interplay between CK1delta and CDK2/E or CDK5/p35. PMID: 26464264
- CK1delta inhibition represents a promising strategy for targeted treatment in human breast cancer with Wnt/beta-catenin involvement. PMID: 26676609
- Expression of truncated hyperactive form of CKIdelta causes mislocalization and aggregation of TDP-43 in cultured cells. PMID: 26769969
- Inhibition of CK1delta increases lipid droplet formation and proliferation of both cancer and normal cells specifically under hypoxia and in an HIF-1alpha- and lipin-1-dependent manner. PMID: 25744540
- site-specific phosphorylation of adiponectin, especially at sites targeted by CK1delta in vitro, provides an additional regulatory mechanism for modulating adiponectin complex formation and function. PMID: 25724478
- Results indicate that changes in the expression levels of casein kinase 1 isoforms CK1delta and DK1epsilon in colorectal tumors correlate with patients' survival. PMID: 25404202
- CK1delta and CK1epsilon play a decisive role in triggering late steps of pre-40S maturation that are required for acquisition of functionality of 40S ribosomal subunits in protein translation. PMID: 24424021
- role for CK1delta in controlling the cell cycle PMID: 24817118
- molecular docking studies to examine the effect of the S97 mutation on its ATP-binding affinity; results explained the underlying molecular mechanism behind the observed cancer associated phenotype caused by S97C mutation in CK1delta protein PMID: 23527964
- decreases in CKIdelta activity can contribute to the pathogenesis of migraine. PMID: 23636092
- These results do not support that genetic variation in CSNK1D and CSNK1E is a susceptibility factor for major psychiatric disorders in the Japanese population. PMID: 22981886
- Casein kinase 1 proteomics reveal prohibitin 2 function in molecular clock PMID: 22384121
- casein kinase 1-delta phosphorylation of PGC-1alpha within its arginine/serine-rich domain enhances its degradation through the proteasome system PMID: 22052997
- CKIdelta-EB1 complexes contribute to the increase in microtubule growth speeds observed in polarized T cells, a mechanism that might serve to generate long-stable microtubules necessary for centrosome translocation. PMID: 22123863
- These results provide strong evidence that the centrosomal localization of CK1delta is required for Wnt-3a-dependent neuritogenesis. PMID: 21422228
- Site-directed mutagenesis demonstrated that only Ser-74 phosphorylation was involved in deoxycytidine kinase (dCK) activation by CKI delta, strengthening the key role of this residue in the control of dCK activity. PMID: 20637175
- findings support a model in which sub-cellular localization at the centrosome is mediated, at least in part, through the action of CG-NAP/AKAP450 PMID: 12270714
- Ckidelta phosphorylates tau at sites that modulate tau/microtubule binding, and that the expression pattern of Ckidelta in Alzheimer's disease is consistent with it playing an important role in tau aggregation PMID: 14761950
- identification of a missense mutation (T44A) in the human CKIdelta gene, which results in familial advanced sleep phase syndrome; CKIdelta is a central component in the mammalian clock PMID: 15800623
- Inhibition of HCKID alters mitotic spindle formation and induces apoptosis in trophoblast cells. PMID: 16027726
- Novel human CKIdelta mutation R324H may alter the physiological role and enhance the transforming ability of CKIdelta through a Wnt/beta-catenin independent mechanism and thereby influence colonic adenoma development. PMID: 17131344
- phosphorylation sites in tau from Alzheimer brain show that casein kinase 1delta may have a role, together with glycogen synthase kinase-3beta, in the pathogenesis of Alzheimer disea PMID: 17562708
- Signal transduction pathway is defined downstream of CCK2 receptor showing that CK1 delta and epsilon phosphorylate PKD2 at 3 sites, resulting in nuclear accumulation of PKD2 and phosphorylation of nuclear PKD2 substrates in human gastric cancer cells. PMID: 17962809
- The degradation rate of PER2, which is regulated by CKIepsilon/delta-dependent phosphorylation, was temperature-insensitive in living clock cells. PMID: 19805222
- identified CK1delta/epsilon as new regulators of YAP and uncovered an intricate mechanism of YAP regulation PMID: 20048001
- Meta-analysis and HuGE review of genotype prevalence, gene-disease association, gene-gene interaction, and gene-environment interaction. (HuGE Navigator) PMID: 11218372
顯示更多
收起更多
-
相關疾病:Advanced sleep phase syndrome, familial, 2 (FASPS2)
-
亞細胞定位:Cytoplasm. Nucleus. Cytoplasm, cytoskeleton, microtubule organizing center, centrosome. Cytoplasm, perinuclear region. Cell membrane. Cytoplasm, cytoskeleton, spindle. Golgi apparatus. Note=Localized at mitotic spindle microtubules, and at the centrosomes and interphase in interphase cells. Recruited to the spindle apparatus and the centrosomes in response to DNA-damage. Correct subcellular localization requires kinase activity.
-
蛋白家族:Protein kinase superfamily, CK1 Ser/Thr protein kinase family, Casein kinase I subfamily
-
組織特異性:Expressed in all tissues examined, including brain, heart, lung, liver, pancreas, kidney, placenta and skeletal muscle. However, kinase activity is not uniform, with highest kinase activity in splenocytes. In blood, highly expressed in hemopoietic cells a
-
數據庫鏈接:
Most popular with customers
-
YWHAB Recombinant Monoclonal Antibody
Applications: ELISA, WB, IHC, IF, FC
Species Reactivity: Human, Mouse, Rat
-
Phospho-YAP1 (S127) Recombinant Monoclonal Antibody
Applications: ELISA, WB, IHC
Species Reactivity: Human
-
-
-
-
-
-